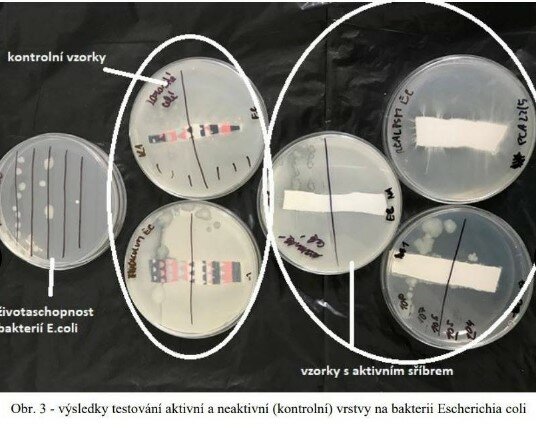
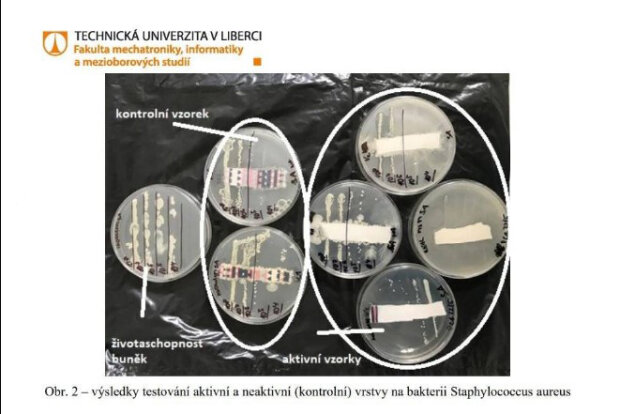

Na začátku epidemie koronaviru Nela slíbila lidem, že bude prodávat hygienické výrobky, aby doplnila nedostatek těchto prostředků. Plánovala prodávat roušky a dezinfekční gely, které by mohly zabránit infekci virem.
Podnikatelka prozradila, že ve složení roušek a gelů bude stříbro, které dokáže zabít nový virus.

Po těchto výrocích redakce eXtra.cz obrátila se na Technickou univerzitu v Liberci, aby kvalitu roušek prověřila. Ukázalo se, že mikroorganismy mohou procházet rouškami jako cedníkem.
Když to vyšlo najevo, Česká obchodní inspekce zahájila řízení proti Slovákové a její prodeji roušek.
Připomeňme, že na jaře Slováková, účastnice reality show Hotel Paradise, údajně upřímně chtěla pomoci lidem v Česku vyhnout se nedostatku individuálních prostředků na ochranu před virem.
Za předražené ceny začala prodávat antibakteriální gely a roušky. Jak se později ukázalo, gely ještě nebyli v prodeji, nebyli ani ve skladu.
Pak přišla řada na závoje, které podle ujištění podnikatelky obsahovaly aktivní stříbro, které je schopné zadržovat bakterie a viry.
„Pokud si nějaké trdlo myslí, že ušitá rouška doma na stroji zachrání nebo pomůže, tak nepomůže. Ani trošku. Rouška ušitá z domácího trička vám bude k ničemu,“ ještě nedávno tvrdila Nela Slováková.
Z kontrol vyplynulo, že roušky, které Slováková prodává, jsou stejně účinné jako kus látky nebo bavlněné tričko.
„Tato metoda spočívala ve vytvoření bakteriální suspenze, která byla přetírána přes látku jak aktivní, tak kontrolní v různých koncentracích pro důkaz inhibičního efektu pomocí aktivního stříbra. Podle výsledků je patrné, že ani kontrolní, ani látka s aktivním stříbrem nevykazovala rozdíl, a tudíž nebyla prokázána její antibakteriálnost.

Minulý rok versus tento rok: Berenika Kohoutová odpočítává dny do porodu
"Já jsem se z toho ještě nevzpamatoval": Odešel za Šafránkovou na nebesa Josef Abrhám
Nebojácná kočka bránila své majitele před obrovským medvědem: Jak skončil souboj obou zvířat
Jak vypadá opravdové medvědí doupě zevnitř
Z tohoto lze usuzovat, že textilie s aktivním stříbrem neobsahovala žádné částice stříbra nebo tyto částice nebyly pevně vázány na textilii a již se v aktivní vrstvě nevyskytovaly,“ zní část textu z výsledného protokolu.

Výsledkem těchto analýz bylo zahájeno správní řízení proti Slovácku.
Nad obchodem Nely začínají houstnout mraky. K události se vyjádřil i mluvčí ČOI Jiří Fröhlich: „Zatím vám nic bližšího nemohu sdělit. Výsledky by měly být známy na začátku září. Pokud se ale slečna Nela Slováková odvolá, mohlo by se to protáhnout ještě o půl roku“.
Zdroj: extra.cz
Zdroj foto: extra.cz
Dříve jsme psali: „JÁ HANCE URČITĚ DÁVNO ODPUSTILA”: PO ODCHODU DO NEBE SE DOČKALA ODPUŠTĚNÍ OD BLÍZKÉHO ČLOVĚKA
Připomínáme: KUP SI BYT A ŽIJ SAMOSTATNĚ: RODIČE VYSTĚHOVALI SVÉHO 30LETÉHO NEZAMĚSTNANÉHO SYNA PŘES SOUD





































